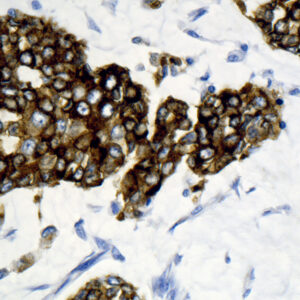
Anti-Epithelial Membrane Antigen (EMA)

Both
Showing 641–660 of 703 resultsSorted by latest
-

Anti-Placental Alkaline Phosphatase (PLAP)
Price range: $260.00 through $1,119.00 Select options This product has multiple variants. The options may be chosen on the product page -

Anti-Myeloid Specific Antigen BM-3
Price range: $269.00 through $935.00 Select options This product has multiple variants. The options may be chosen on the product page -

Anti-Mitochondrial Antigen
Price range: $250.00 through $1,549.00 Select options This product has multiple variants. The options may be chosen on the product page -

Anti-Granulocyte
Price range: $223.00 through $905.00 Select options This product has multiple variants. The options may be chosen on the product page -

Anti-Cytokeratin 10
Price range: $250.00 through $1,125.00 Select options This product has multiple variants. The options may be chosen on the product page -

Anti-p53 Protein
Price range: $260.00 through $1,275.00 Select options This product has multiple variants. The options may be chosen on the product page -

Anti-pS2 Estrogen Inducible Protein
Price range: $260.00 through $935.00 Select options This product has multiple variants. The options may be chosen on the product page -
Anti-Epithelial Membrane Antigen (EMA)
Price range: $250.00 through $965.00 Select options This product has multiple variants. The options may be chosen on the product page -

Anti-Cytokeratin, Pan
Price range: $250.00 through $1,235.00 Select options This product has multiple variants. The options may be chosen on the product page -

Anti-Beta-Tubulin IV
Price range: $269.00 through $859.00 Select options This product has multiple variants. The options may be chosen on the product page -

Anti-Beta-Tubulin III
Price range: $355.00 through $905.00 Select options This product has multiple variants. The options may be chosen on the product page -

Anti-Beta-Tubulin II
Price range: $350.00 through $905.00 Select options This product has multiple variants. The options may be chosen on the product page -

Anti-Heat Shock Protein 27 (HSP 27)
Price range: $260.00 through $979.00 Select options This product has multiple variants. The options may be chosen on the product page -

Anti-Collagen III
Price range: $250.00 through $975.00 Select options This product has multiple variants. The options may be chosen on the product page -

Anti-Macrophage
Price range: $250.00 through $935.00 Select options This product has multiple variants. The options may be chosen on the product page -

Anti-Myeloid Specific Antigen BM-1
Price range: $269.00 through $935.00 Select options This product has multiple variants. The options may be chosen on the product page -

Anti-Vimentin
Price range: $250.00 through $1,035.00 Select options This product has multiple variants. The options may be chosen on the product page -

Anti-B Cell
Price range: $250.00 through $1,035.00 Select options This product has multiple variants. The options may be chosen on the product page -

Anti-CD45RC (T Cell)
Price range: $260.00 through $1,320.00 Select options This product has multiple variants. The options may be chosen on the product page -

Anti-HLA-DR
Price range: $250.00 through $1,275.00 Select options This product has multiple variants. The options may be chosen on the product page
